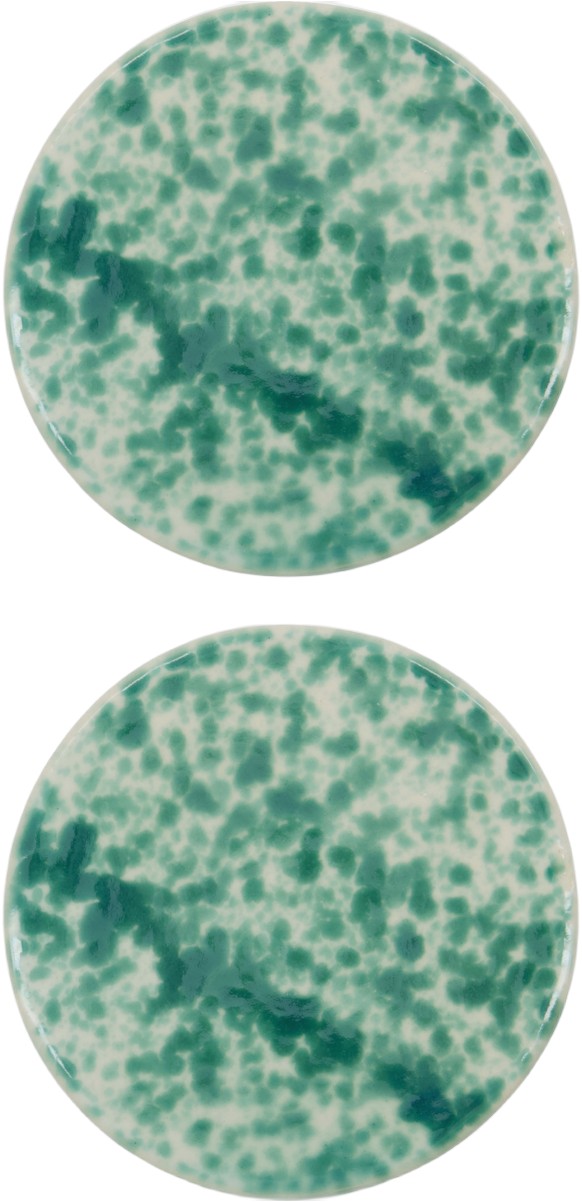
Serveringsbræt, Hddiva, Grøn

House Doctor tallerkner
Rustic, Lake og Pion tallerkner i porcelæn er designet in-house. House Doctor fremstiller tallerkener med nøje udvalgte producenter. Dække op med en rustik og afslappet tallerken i en grå, off-white eller sort farve fra House Doctor.
Populær i House Doctor tallerkner
-
House Doctor Pion Pastatallerken 25 Cm Sort / - Pastatallerkner Stentøj Brun - 206260206
149 kr
Læs mere herPastatallerknen fra House Doctor har et stilrent, diskret design i stentøj med rustikke pletter og en rund form perfekt til servering af pasta. Kombinér med andre dele i serien og skab dit eget personlige look. Hver artikel er unik og kan variere en anelse i udseende. Om pastatallerknen fra House Doctor- Stilrent, diskret design.- Fremstillet af stentøj.- Rustikke pletter.- Rund form.- Højde: 65 mm.- Diameter: 250 mm. Vedligeholdelse af pastatallerknen- Tåler opvaskemaskine- Tåler mikroovn. Køb Pastatallerkner og andre Tallerkner fra Royal Design. -
House Doctor Pion Pastatallerken 25 Cm Hvid / - Pastatallerkner Stentøj Grå - 206260106
140 kr
Læs mere herPastatallerknen fra House Doctor har et stilrent, diskret design i stentøj med rustikke pletter og en rund form perfekt til servering af pasta. Kombinér med andre dele i serien og skab dit eget personlige look. Hver artikel er unik og kan variere en anelse i udseende. Om pastatallerknen fra House Doctor- Stilrent, diskret design.- Fremstillet af stentøj.- Rustikke pletter.- Rund form.- Højde: 65 mm.- Diameter: 250 mm. Vedligeholdelse af pastatallerknen- Tåler opvaskemaskine- Tåler mikroovn. Køb Pastatallerkner og andre Tallerkner fra Royal Design. -
House Doctor Pion pastatallerken Ø25 cm Sort/Brun
House Doctor Pion pastatallerken Ø25 cm Sort/Brun -
House Doctor Pion Serveringsfad 36 Cm t / Hvidt - Serveringsfad Stentøj Grå - 206260121
199 kr
Læs mere herServeringsfadet fra House Doctor har et stilrent, diskret design i stentøj med rustikke pletter og en rund form perfekt til servering af alt fra sprøde salater til grøntsager og snacks. Kombinér med andre dele i serien og skab dit eget personlige look. Hver artikel er unik og kan variere en smule i udseende. Om serveringsfadet fra House Doctor- Stilrent, diskret design.- Fremstillet af stentøj.- Rustikke pletter.- Rund form.- Højde: 45 mm.- Diameter: 360 mm. Vedligeholdelse af serveringsfadet- Tåler opvaskemaskine- Tåler mikroovn. Køb Serveringsfad og andre Skåle & Serveringsfade fra Royal Design.
Flere tips på House Doctor tallerkner
-
House Doctor Diva Frokosttallerken Ø22,5 Cm - Middagstallerkner Stentøj Lyseblå - 267600032
96 kr
Læs mere herFrokosttallerken fra House Doctor med et håndlavet design i stentøj med en moderne følelse perfekt til hverdag og finere anledninger.Om frokosttallerknen fra House Doctor- Håndlavet af holdbart stentøj.- Supplerer Diva-kollektionen.- Moderne design til ethvert miljø.. Køb Middagstallerkner og andre Tallerkner fra Royal Design. -
House Doctor More tallerken Ø27 cm Grå
House Doctor More tallerken Ø27 cm Grå -
House Doctor Pion Tallerken 21,5 Cm Hvid / - Middagstallerkner Stentøj Grå - 206260104
75 kr
Læs mere herTallerkenen fra House Doctor har et stilrent, diskret design i stentøj med rustikke pletter og en rund form perfekt til frokoster. Kombinér med andre dele i serien og skab dit eget personlige look. Hver artikel er unik og kan variere en anelse i udseende. Om tallerkenen fra House Doctor- Stilrent, diskret design.- Fremstillet af stentøj.- Rustikke pletter.- Rund form.- Højde: 30 mm.- Diameter: 215 mm. Vedligeholdelse af tallerkenen- Tåler opvaskemaskine- Tåler mikroovn. Køb Middagstallerkner og andre Tallerkner fra Royal Design. -
House Doctor Pion serveringsfad 12x35 cm Sort/Brun
House Doctor Pion serveringsfad 12x35 cm Sort/Brun -
Tallerken, Hddiva, Blå
229 kr
Læs mere herGiv din spiseoplevelse et løft med denne udsøgte hånd-aint -
House Doctor Rain tallerken Ø27 cm 2-pak Klar
House Doctor Rain tallerken Ø27 cm 2-pak Klar -
House Doctor Hddiva Serveringsfad 2-pak t - Serveringsfad Stentøj Grøn - 267600020
146 kr
Læs mere herServeringsfad fra House Doctor med et rundt design i stentøj med et slående, håndmalet, grønt mønster.Om serveringsfadet fra House Doctor- Håndmalet grønt design.- Alsidige serveringsmuligheder.- Sæt med to dele.. Køb Serveringsfad og andre Skåle & Serveringsfade fra Royal Design. -
House Doctor Pion Serveringsfad 36 Cm Sort / t - Serveringsfad Stentøj Brun - 206260221
332 kr
Læs mere herServeringsfadet fra House Doctor har et stilrent, diskret design i stentøj med rustikke pletter og en rund form perfekt til servering af alt fra sprøde salater til grøntsager og snacks. Kombinér med andre dele i serien og skab dit eget personlige look. Hver artikel er unik og kan variere en smule i udseende. Om serveringsfadet fra House Doctor- Stilrent, diskret design.- Fremstillet af stentøj.- Rustikke pletter.- Rund form.- Højde: 45 mm.- Diameter: 360 mm. Vedligeholdelse af serveringsfadet- Tåler opvaskemaskine- Tåler mikroovn. Køb Serveringsfad og andre Skåle & Serveringsfade fra Royal Design. -
House Doctor Pion morgenmadstallerken Ø21,5 cm Sort/Brun
House Doctor Pion morgenmadstallerken Ø21,5 cm Sort/Brun -
House Doctor Pion Tallerken 21,5 Cm Sort / - Middagstallerkner Stentøj Brun - 206260204
69 kr
Læs mere herTallerkenen fra House Doctor har et stilrent, diskret design i stentøj med rustikke pletter og en rund form perfekt til frokoster. Kombinér med andre dele i serien og skab dit eget personlige look. Hver artikel er unik og kan variere en anelse i udseende. Om tallerkenen fra House Doctor- Stilrent, diskret design.- Fremstillet af stentøj.- Rustikke pletter.- Rund form.- Højde: 30 mm.- Diameter: 215 mm. Vedligeholdelse af tallerkenen- Tåler opvaskemaskine- Tåler mikroovn. Køb Middagstallerkner og andre Tallerkner fra Royal Design. -
House Doctor Lake serveringsfad Ø30 cm Grøn
House Doctor Lake serveringsfad Ø30 cm Grøn -
House doctor Pion kagetallerken, hvid/grå
48 kr
Læs mere herNu kan du både spise kagen og beholde den takket være kagetallerkenen fra House Doctor. Pion er en porcelænstallerken med en rustik hvidt/gråt meleret design, der giver tallerkenen et afslappet design, men præsenterer dine kager på fineste måde. Den neutr -
House Doctor Pion Middagstallerken 28,5 Cm Hvid / - Middagstallerkner Stentøj Grå - 206260105
99 kr
Læs mere herMiddagstallerknen fra House Doctor har et stilrent, diskret design i stentøj med rustikke pletter og en rund form perfekt til middagsselskaber. Kombinér med andre dele i serien og skab dit eget personlige look. Hver artikel er unik og kan variere en anelse i udseende. Om middagstallerknen fra House Doctor- Stilrent, diskret design.- Fremstillet af stentøj.- Rustikke pletter.- Rund form.- Højde: 35 mm.- Diameter: 285 mm. Vedligeholdelse af middagstallerknen- Tåler opvaskemaskine- Tåler mikroovn. Køb Middagstallerkner og andre Tallerkner fra Royal Design. -
House Doctor Rustic suppetallerken Ø25 cm Mørkegrå
House Doctor Rustic suppetallerken Ø25 cm Mørkegrå -
House Doctor Pion Serveringsfad t/hvidt - Serveringsfad Stentøj Grå - 206260235
229 kr
Læs mere herServeringsfad fra House Doctor med rustikt, moderne design i glaseret stentøj med mat finish perfekt til hverdagsbrug, morgenmad eller eftermiddagskaffe. Det har et praktisk håndtag på siden med en matchende underkop. Serveringsfadet har et unikt, spraglet mønster. Hver artikel er unik og kan variere en anelse i udseende. Om serveringsfadet fra House Doctor- 19,6 x 30,9 cm- Fremstillet af stentøj.- Findes også som kaffekop.. Køb Serveringsfad og andre Skåle & Serveringsfade fra Royal Design. -
House Doctor Diva Frokosttallerken Ø22,5 Cm - Middagstallerkner Stentøj Blå - 267600015
102 kr
Læs mere herFrokosttallerken fra House Doctor med et håndlavet design i stentøj med et dekorativt, blåt mønster og en tidløs følelse perfekt til hverdag og finere anledninger.Om frokosttallerknen fra House Doctor- Håndlavet af holdbart stentøj.- Supplerer Diva-kollektionen.. Køb Middagstallerkner og andre Tallerkner fra Royal Design. -
House Doctor More tallerken Ø23 cm Grå
House Doctor More tallerken Ø23 cm Grå -
House Doctor Pion serveringsfad Ø36 cm Sort/Brun
House Doctor Pion serveringsfad Ø36 cm Sort/Brun -
House Doctor Suns tallerken Ø15,7 cm Mørkegrå
House Doctor Suns tallerken Ø15,7 cm Mørkegrå -
House Doctor More Middagstallerken Ø23 Cm - Middagstallerkner Stentøj Grå - 267710006
69 kr
Læs mere herMiddagstallerken fra House Doctor med et tidløst design i stentøj med en mat glasering perfekt for at skabe en harmonisk og elegant bordopdækning.Om middagstallerknen fra House Doctor- Mat grå finish.- Tidløst design.. Køb Middagstallerkner og andre Tallerkner fra Royal Design. -
House doctor Pleat middagstallerken Ø27 cm, grå/brun
83 kr
Læs mere herMiddagstallerkenen i serien Pleat fra House Doctor tilføjer en subtil, men elegant flair til dit bord. Den karakteristiske, riflede overflade kombinerer en mat finish på ydersiden med en glansfuld inderside, hvilket giver tallerkenen et stilfuldt og raffi -
House Doctor Rustic tallerken 27,5 cm
House Doctor Rustic tallerken 27,5 cm -
House Doctor Lake Tallerken 27cm - Middagstallerkner Stentøj Grå - 206260323
89 kr
Læs mere herEn smuk plade fra serie serien af House Doctor. Pladen har et rustikt og rå udseende med sin skrøbelige overflade og dim farver. Materialet består af stentøj og har en glaseret overflade. Kombiner med andre produkter fra søområdet. Variationer i struktur, farve og størrelse kan forekomme på grund af produktets håndlavede natur.. Køb Middagstallerkner og andre Tallerkner fra Royal Design. -
House Doctor Rustic Tallerken Ø27,5 Cm Grå / Blå - Middagstallerkner Keramik Gråblå - 206260800
85 kr
Læs mere herTallerkenen fra House Doctor har et håndlavet design i keramik med et rustikt look og en smuk glasering som passer harmonisk ind i omgivelserne. Mindre variationer kan forekomme på grund af det omhyggeligt håndlavede design. En perfekt detalje på det opdækkede bord. Om tallerkenen fra House Doctor- Denne tallerken er en del af House Doctor-kollektionen.- Håndlavet design.- Rustikt look.- Smuk glasering.- Tallerkenen passer godt i køkkenet.- Diameter: 275 mm.- Højde: 28 mm.- Tallerkenen findes i forskellige farver. Vedligeholdelse af tallerkenen- Tåler mikroovn- Tåler opvaskemaskine. Køb Middagstallerkner og andre Tallerkner fra Royal Design. -
House Doctor Pion Dyb Tallerken 19 Cm Sort / - Dybe tallerkner Stentøj Brun - 206260207
79 kr
Læs mere herDen dybe tallerken fra House Doctor har et stilrent, diskret design i stentøj med rustikke pletter og en rund form perfekt til servering af både aftensmad og morgenmad. Kombinér med andre dele i serien og skab dit eget personlige look. Hver artikel er unik og kan variere en anelse i udseende. Om den dybe tallerken fra House Doctor- Stilrent, diskret design.- Fremstillet af stentøj.- Rustikke pletter.- Rund form.- Højde: 40 mm.- Diameter: 190 mm. Vedligeholdelse af den dybe tallerken- Tåler opvaskemaskine- Tåler mikroovn. Køb Dybe tallerkner og andre Tallerkner fra Royal Design. -
Serveringsbræt, Hddiva, Brun
229 kr
Læs mere herPrimær: Stentøj (100%) -
Tallerkenopsats, Hdsana, Sølv Finish
499 kr
Læs mere herPrimær: Rustfrit stål (100%) -
House Doctor Diva Frokosttallerken Ø16 Cm - Asietter Stentøj Grøn - 267600029
100 kr
Læs mere herFrokosttallerken fra House Doctor med et håndlavet design i stentøj med et dekorativt, grønt, spraglet mønster. Kombinér med andre dele i serien og skab dit eget personlige look.Om frokosttallerknen fra House Doctor- Håndlavet af holdbart stentøj.- Supplerer Diva-kollektionen.. Køb Asietter og andre Tallerkner fra Royal Design. -
House Doctor Pleat middagstallerken Ø27 cm Grå-brun
House Doctor Pleat middagstallerken Ø27 cm Grå-brun -
House Doctor Hddiva Serveringsbakke 25 Cm - Serveringsfad Lertøj Lyseblå - 267600003
169 kr
Læs mere herServeringsbakke fra House Doctor med et håndlavet design i lertøj med en blank glasering og æstetisk, unik karakter perfekt til at live borddækningen op.Fremstillet i Indien.Om serveringsbakken fra House Doctor- Håndlavet tønde i stentøj.- Glansfuld lyseblå finish.- Ideel til alsidig servering.- Tidløst design med karakter.. Køb Serveringsfad og andre Skåle & Serveringsfade fra Royal Design. -
House doctor Mere lunchtallerken 23 cm, grå
69 kr
Læs mere herTilføj et elegant element til borddækningen med More frokosttallerken fra House Doctor. Tallerkenen er lavet af stentøj med matgrå glasur og en unik form, der kendetegnes ved sine små ufuldkommenheder, hvilket tilføjer charme og håndværksmæssig følelse ti -
House Doctor Rain Tallerken 2-pak 27 Cm - Middagstallerkner Glas Aqua - 262680001
168 kr
Læs mere herTallerkenen fra House Doctor er fremstillet af glas med små, dekorative luftbobler som gør hvert eksemplar unikt. Perfekt til at live borddækningen op. Kombinér med andre dele i serien og skab dit eget personlige look. Om tallerkenen fra House Doctor- Fremstillet af glas.- Vælg mellem forskellige farver og størrelser.- Fra kollektionen Rain.- Sælges i 2-pak.- Kombinér tallerkenen med andre produkter fra kollektionen fra House Doctor. Vedligeholdelse af tallerkenen- Tåler opvaskemaskine. Køb Middagstallerkner og andre Tallerkner fra Royal Design. -
House Doctor Pion pastatallerken Ø25 cm Grå/Hvid
House Doctor Pion pastatallerken Ø25 cm Grå/Hvid -
House doctor Lake tallerken grå Ø27 cm.
80 kr
Læs mere herDenne tallerken fra House Doctor er en del af den rustikke Lake serie, der tilfører masser af karakter til borddækningen. Tallerkenen er fremstillet af porcelæn, og den kommer desuden i forskellige farver og størrelser, så du kan finde dit perfekte match. -
House Doctor Lake tallerken grå 15.2 cm
House Doctor Lake tallerken grå 15.2 cm -
House Doctor Rustic Brunchsæt 16 Dele t/blåt - Service & Startsæt Stentøj Grå - 257981012
899 kr
Læs mere herBrunchsæt fra House Doctor i slidstærkt stentøj med et unikt, naturligt look og varierede, grå, blå farver perfekt til hverdagsbrug, morgenmad eller eftermiddagskaffe.Om Brunchsættet fra House Doctor- 16 dele.- Dette bruchsæt indeholder 4x tallerkener, 4x skåle, 4x te-/kaffekopper, 4x æggebægre.- Fra kollektionen Rustic.- Fremstillet af stentøj.- Der kan forekomme farveforskelle, hvilket gør hvert stykke unikt.Vedligeholdelse af Brunchsættet- Tåler mikroovn.- Tåler opvaskemaskine.. Køb Service & Startsæt og andre Tallerkner fra Royal Design. -
Skærebræt, Hdeya, Natur
329 kr
Læs mere herAkacietræ -
House doctor Rustic Kagetallerken
60 kr
Læs mere herHop med på stentøjs vognen. Med Rustic Kagetallerkenen fra House Doctor, får du et helt unikt design i nordisk og moderne look. Kagetallerknen er som navnet antyder perfekt til kager, men den er også ideel til at servere frugt eller snacks på. Stentøjet h -
House Doctor Rustic tallerken 20,5 cm
House Doctor Rustic tallerken 20,5 cm -
House Doctor Scallop Tallerken Ø26 Cm - Middagstallerkner Stentøj Lyseblå - 267710016
108 kr
Læs mere herTallerken fra House Doctor med et elegant, håndlavet design i stentøj med en smuk, muslingeformet kant og glaseret finish. Kombinér med andre dele i serien og skab dit eget personlige look.Om tallerkenen fra House Doctor- Fremstillet af stentøj.- Hver artikel er unik og kan variere en anelse i udseende.- Fra kollektionen Scallop.. Køb Middagstallerkner og andre Tallerkner fra Royal Design. -
House doctor Pion tallerken, hvid/grå
69 kr
Læs mere herNyd en skøn morgenmad eller en lækker frokost på tallerkenen fra House Doctor. Den indgår i Pion serien, der har et rustikt, nordisk udtryk og fås i flere afdæmpede farver. De neutrale farver lader dig dække et moderne middagsbord, hvor du kan supplere me -
House Doctor Diva middagstallerken Ø23 cm Blå
House Doctor Diva middagstallerken Ø23 cm Blå -
House doctor More Tallerken Ø27, grå
82 kr
Læs mere herSlip din kreativitet løs og skab kunstneriske opdækninger med More stengodstallerken fra House Doctor. Tallerkenen har en smuk matgrå glasur, der tilføjer en tidløs kvalitet til bordet. Den unikke, ujævne form gør hver del speciel - perfekt til at skabe -
House Doctor Pion tallerken Ø28,5 cm Grå/Hvid
House Doctor Pion tallerken Ø28,5 cm Grå/Hvid -
House Doctor Diva tallerken Ø28 cm Rød
House Doctor Diva tallerken Ø28 cm Rød -
House Doctor Mini Diva Tallerken sæt, blå
161 kr
Læs mere herLyft borddækningen med noget, der skiller sig ud - Mini Diva er et tallerkensæt i stentøj fra House Doctor, som virkelig fanger blikket. Hver tallerken er håndmalet med dybblå blomster og blade mod en varm cremet hvid bund. Resultatet? En livlig og pers -
House Doctor Scallop Tallerken Ø20 Cm - Middagstallerkner Stentøj Lyseblå - 267710017
70 kr
Læs mere herTallerken fra House Doctor med et elegant, håndlavet design i stentøj med en smuk, muslingeformet kant og glaseret finish. Kombinér med andre dele i serien og skab dit eget personlige look.Om tallerkenen fra House Doctor- Fremstillet af stentøj.- Hver artikel er unik og kan variere en anelse i udseende.- Fra kollektionen Scallop.. Køb Middagstallerkner og andre Tallerkner fra Royal Design. -
House Doctor Pleat Pastatallerken 26 Cm Gråbrun - Pastatallerkner Stentøj Grey Brown - 206260247
146 kr
Læs mere herPastatallerken fra House Doctor med et ribbet design i stentøj med en mat yderside og en skinnende inderside for et sofistikeret og elegant touch. Fremstillet i Kina. Originaldesign fra 2024. Om pastatallerknen fra House Doctor- Pleat er værdsat for det ribbede design- Fra kollektionen HDPleat.- Fremstillet af stentøj. Vedligeholdelse af pastatallerknen- Tåler mikroovn- Tåler opvaskemaskine. Køb Pastatallerkner og andre Tallerkner fra Royal Design. -
House Doctor Pion serveringsfad Ø36 cm Grå/Hvid
House Doctor Pion serveringsfad Ø36 cm Grå/Hvid -
Kagetallerken, Hddiva, Grøn
129 kr
Læs mere herPrimær: Stentøj (100%) -
House Doctor Lake Frokosttallerken 21,4cm - Middagstallerkner Stentøj Grå - 206260324
67 kr
Læs mere herEn smuk frokostplade fra Lake Series af House Doctor. Pladen har et rustikt og rå udseende med sin skrøbelige overflade og dim farver. Materialet består af stentøj og har en glaseret overflade. Kombiner med andre produkter fra søområdet.. Køb Middagstallerkner og andre Tallerkner fra Royal Design. -
House Doctor Seny Dekorationstallerken Antik Messing - øvrige-tallerkner-fad Rustfrit Stål Antique Brass - 203662009
587 kr
Læs mere herDekorationstallerken fra House Doctor med et elegant stativ i messingbelagt stål med plateauer i forskellige niveauer perfekt til at live borddækningen op.Om dekorationstallerknen fra House Doctor- Fremstillet af rustfrit stål.- h: 40 cm, dia: 18 cm.Vedligeholdelse af dekorationstallerknen- Rengøres med en fugtig klud.. Køb øvrige-tallerkner-fad og andre Tallerkner fra Royal Design. -
House doctor Diva frokosttallerken 23 cm, blå
99 kr
Læs mere herDiva tallerken fra House Doctor har et håndmalet blåt mønster, der gør det nemt at introducere mønster til borddækningen. Tallerkenen er lavet af stentøj, hvilket både gør den praktisk og giver et hyggeligt udtryk til borddækningen. Tallerkenen kan med fo -
House Doctor Pion serveringsfad 19x38 cm Sort/Brun
House Doctor Pion serveringsfad 19x38 cm Sort/Brun -
House Doctor Hddiva Serveringsfad 2-pak t - Serveringsfad Stentøj Blå - 267600021
173 kr
Læs mere herServeringsfad fra House Doctor med et rundt design i stentøj med et slående, håndmalet, blåt mønster.Om serveringsfadet fra House Doctor- Håndmalet blåt design.- Alsidige serveringsmuligheder.- Sæt med to dele.. Køb Serveringsfad og andre Skåle & Serveringsfade fra Royal Design. -
House doctor Pion middagstallerken, hvid/grå
99 kr
Læs mere herEn dejlig middag præsenteres godt på House Doctors Pion middagstallerken. Den indgår i Pion serien, der har et rustikt, nordisk udtryk og fås i flere afdæmpede farver. De neutrale farver lader dig dække et moderne middagsbord, hvor du kan supplere med bla -
House Doctor Lake tallerken grå 21.4 cm
House Doctor Lake tallerken grå 21.4 cm -
House Doctor Diva Tallerken - Asietter Stentøj Blå - 267600050
161 kr
Læs mere herDiva-tallerkenerne fra House Doctor er designet til både æstetik og funktionalitet. Sættet indeholder tre små tallerkener, hver med unikke blomster- og bladmotiver, der giver hver tallerken sin egen karakter. Perfekt til små portioner, appetitvækkere eller som dekorative elementer på bordet. Kombiner dem med ensfarvet keramik for at skabe dit eget smukke miks.Om tallerkenen fra House DoctorOm tallerkenen fra House Doctor- - Tidløst blå-hvidt design med unikke mønstre.- Perfekt til små portioner eller forretter.- Kan kombineres med ensfarvet keramik.- Tilføjer et kunstnerisk og elegant præg til borddækningen.Vedligeholdelse af tallerkenen. Køb Asietter og andre Tallerkner fra Royal Design. -
House Doctor Ash tallerken 21,6 cm Grå/Blå
House Doctor Ash tallerken 21,6 cm Grå/Blå -
House Doctor Rustic Suppetallerken 25cm - Dybe tallerkner Keramik Gråblå - 206260802
82 kr
Læs mere herSkøn suppetallerken i porcelæn med glaseret overflade i grå nuance. Alle dele i serien Rustic er håndlavet og kan variere i designet.Tåler opvaskemaskine.. Køb Dybe tallerkner og andre Tallerkner fra Royal Design. -
House Doctor Scallop Tallerken Ø26 Cm - Middagstallerkner Stentøj Rosa - 900000234
130 kr
Læs mere herTallerken fra House Doctor med et elegant, håndlavet design i stentøj med en smuk, muslingeformet kant og glaseret finish. Kombinér med andre dele i serien og skab dit eget personlige look.Om tallerkenen fra House Doctor- Fremstillet af stentøj.- Hver artikel er unik og kan variere en anelse i udseende.- Fra kollektionen Scallop.. Køb Middagstallerkner og andre Tallerkner fra Royal Design. -
House Doctor Pion serveringsfad 19x38 cm Grå/Hvid
House Doctor Pion serveringsfad 19x38 cm Grå/Hvid -
Serveringsbræt, Hddiva, Grøn
229 kr
Læs mere herPrimær: Stentøj (100%) -
Lake serveringsfad 30 cm
229 kr
Læs mere herLake serveringsfadet fra House Doctor gør det nemt at præsentere mad på en indbydende måde. Den mørkegrønne glasur skaber en rolig baggrund, hvor farver og teksturer i dine retter træder tydeligt frem, uanset om du serverer kanapéer, friskbagte boller ell -
Tallerkenopsats, Hdsana, Sølv Finish
499 kr
Læs mere herPrimær: Rustfrit stål (100%) -
Serveringsfad, Hdkala, Sort
269 kr
Læs mere herPrimær: Stentøj (100%) -
House Doctor Pion serveringsfad 12x35 cm Grå/Hvid
House Doctor Pion serveringsfad 12x35 cm Grå/Hvid -
House Doctor Pion morgenmadstallerken Ø21,5 cm Grå/Hvid
House Doctor Pion morgenmadstallerken Ø21,5 cm Grå/Hvid -
House Doctor Lake tallerken grå 27 cm
House Doctor Lake tallerken grå 27 cm -
House Doctor Oak tallerken 21,6 cm Grå/Blå
House Doctor Oak tallerken 21,6 cm Grå/Blå -
House Doctor Pion Desserttallerken 16,5 Cm Hvid / - Asietter Stentøj Grå - 206260103
49 kr
Læs mere herDesserttallerknen fra House Doctor har et stilrent, diskret design i stentøj med rustikke pletter og en rund form perfekt til forskellige forretter og desserter. Kombinér med andre dele i serien og skab dit eget personlige look. Hver artikel er unik og kan variere en anelse i udseende. Om desserttallerknen fra House Doctor- Stilrent, diskret design.- Fremstillet af stentøj.- Rustikke pletter.- Rund form.- Højde: 25 mm.- Diameter: 165 mm. Vedligeholdelse af desserttallerknen- Tåler opvaskemaskine- Tåler mikroovn. Køb Asietter og andre Tallerkner fra Royal Design. -
House Doctor Pleat morgenmadstallerken Ø22 cm Grå-brun
House Doctor Pleat morgenmadstallerken Ø22 cm Grå-brun -
House Doctor Pleat pastatallerken Ø26 cm Grå-brun
House Doctor Pleat pastatallerken Ø26 cm Grå-brun -
Serveringsbræt, Hddiva, Brun
299 kr
Læs mere herPrimær: Stentøj (100%) -
House Doctor Rustic dyb tallerken Ø25 cm
House Doctor Rustic dyb tallerken Ø25 cm -
House Doctor More Middagstallerken Ø27 Cm - Middagstallerkner Stentøj Grå - 267710007
82 kr
Læs mere herMiddagstallerken fra House Doctor med et tidløst design i stentøj med en mat glasering perfekt for at skabe en harmonisk og elegant bordopdækning.Om middagstallerknen fra House Doctor- Mat grå finish.- Tidløst design.. Køb Middagstallerkner og andre Tallerkner fra Royal Design. -
Serveringsbræt, Hddiva, Blå
229 kr
Læs mere herPrimær: Stentøj (100%) -
House doctor Rustic 27,5 cm. Tallerken
80 kr
Læs mere herRustic serien fra House Doctor vil med garanti skabe en flot og anderledes borddækning hos dig. Tallerkenen er skabt af 100 % stentøj, hvilket giver et unikt design med flotte karaktertræk. De passer ind i ethvert hjem med det nordiske og moderne look de -
House doctor Pleat frokosttallerken, grå/brun
82 kr
Læs mere herDen mindre tallerken fra House Doctor er det perfekte valg, når du ønsker en elegant og diskret borddækning til morgenmaden eller frokosten. Tallerkenens raffinerede design kombinerer en mat yderside med en blank inderside, så der skabes en smuk kontrast, -
House Doctor Chestnut tallerken 21,6 cm Grå/Blå
House Doctor Chestnut tallerken 21,6 cm Grå/Blå -
House Doctor Diva tallerken Ø22,5 cm Lyseblå
House Doctor Diva tallerken Ø22,5 cm Lyseblå -
House Doctor Diva Frokosttallerken Ø16 Cm - Asietter Stentøj Lyseblå - 267600030
86 kr
Læs mere herFrokosttallerken fra House Doctor med et håndlavet design i stentøj med en moderne følelse perfekt til hverdag og finere anledninger.Om frokosttallerknen fra House Doctor- Håndlavet af holdbart stentøj.- Supplerer Diva-kollektionen.- Moderne design til ethvert miljø.. Køb Asietter og andre Tallerkner fra Royal Design. -
House Doctor Pleat Tallerken 22 Cm Gråbrun - Middagstallerkner Stentøj Grey Brown - 206260245
82 kr
Læs mere herTallerken fra House Doctor med et ribbet design i stentøj med en mat yderside og en skinnende inderside for et sofistikeret og elegant touch. Fremstillet i Kina. Originaldesign fra 2024. Om tallerkenen fra House Doctor- Pleat er værdsat for det ribbede design- Fra kollektionen HDPleat.- Fremstillet af stentøj. Vedligeholdelse af tallerkenen- Tåler mikroovn- Tåler opvaskemaskine. Køb Middagstallerkner og andre Tallerkner fra Royal Design. -
House Doctor Maki serveringsfad Grå
House Doctor Maki serveringsfad Grå -
House Doctor Diva serveringsfad Ø25 cm Grøn
House Doctor Diva serveringsfad Ø25 cm Grøn -
House Doctor Pion Middagstallerken 28,5 Cm Sort / - Middagstallerkner Stentøj Brun - 206260205
100 kr
Læs mere herMiddagstallerknen fra House Doctor har et stilrent, diskret design i stentøj med rustikke pletter og en rund form perfekt til middagsselskaber. Kombinér med andre dele i serien og skab dit eget personlige look. Hver artikel er unik og kan variere en anelse i udseende. Om middagstallerknen fra House Doctor- Stilrent, diskret design.- Fremstillet af stentøj.- Rustikke pletter.- Rund form.- Højde: 35 mm.- Diameter: 285 mm. Vedligeholdelse af middagstallerknen- Tåler opvaskemaskine- Tåler mikroovn. Køb Middagstallerkner og andre Tallerkner fra Royal Design. -
House Doctor Diva serveringsfad Ø25 cm Lyseblå
House Doctor Diva serveringsfad Ø25 cm Lyseblå -
House Doctor Diva tallerken Ø28 cm Grøn
House Doctor Diva tallerken Ø28 cm Grøn -
House doctor Rain tallerken 27 cm grøn, 2 stk.
109 kr
Læs mere herSæt med to tallerkener i serien Rain fra House Doctor - perfekt til både luksuriøse middagsselskaber og afslappede sommermiddage i haven. Tallerkenerne er lavet af smukt, grønt glas, og hvis du kigger nærmere efter, kan du se de små luftbobler i glasset, -
House Doctor Lake Serveringsfad Ø30 Cm t - Serveringsfad Stentøj Grøn - 206260318
229 kr
Læs mere herServeringsfadet fra House Doctor har et tidløst design i stentøj med en rustik følelse perfekt til at live borddækningen op. Mix og match med andre dele af kollektionen for at skabe en perfekt kombination. Om serveringsfadet fra House Doctor- Dette serveringsfad er en del af House Doctor-kollektionen.- Boheme design.- Fremstillet af stentøj.- Findes også som matchende skål.- Serveringsfadet findes i forskellige farver.- Diameter: 300 mm.- Højde: 40 mm. Vedligeholdelse af serveringsfadet- Tåler opvaskemaskine- Tåler mikroovn. Køb Serveringsfad og andre Skåle & Serveringsfade fra Royal Design. -
House Doctor Rustik Tallerken 20 Cm - Asietter Keramik Gråblå - 206260801
62 kr
Læs mere herEn tallerken fra House Doctor i stentøj, der fungerer som den perfekte baggrund for dine hjemmelavede kager. Den unikke gråblå glasur kan variere i nuance fra produkt til produkt, hvilket giver hver tallerken et rustikt og personligt præg, der løfter både hverdagens øjeblikke og festlige lejligheder. Lavet af slidstærkt stentøj. Unik gråblå glasur, der varierer mellem produkter. Perfekt til kager og desserter. Giver et personligt præg til borddækningen.. Køb Asietter og andre Tallerkner fra Royal Design. -
House Doctor Hddiva Middagstallerken 28 Cm - Middagstallerkner Stentøj Rød - 267600034
119 kr
Læs mere herMiddagstallerken fra House Doctor med et håndlavet design i stentøj med en moderne følelse perfekt til hverdag og finere anledninger.Om middagstallerknen fra House Doctor- Håndlavet af holdbart stentøj.- Supplerer HDDiva-kollektionen.- Moderne design til ethvert miljø.. Køb Middagstallerkner og andre Tallerkner fra Royal Design. -
House Doctor Pion Dyb Tallerken 19 Cm Hvid / - Dybe tallerkner Stentøj Grå - 206260107
70 kr
Læs mere herDen dybe tallerken fra House Doctor har et stilrent, diskret design i stentøj med rustikke pletter og en rund form perfekt til servering af både aftensmad og morgenmad. Kombinér med andre dele i serien og skab dit eget personlige look. Hver artikel er unik og kan variere en anelse i udseende. Om den dybe tallerken fra House Doctor- Stilrent, diskret design.- Fremstillet af stentøj.- Rustikke pletter.- Rund form.- Højde: 40 mm.- Diameter: 190 mm. Vedligeholdelse af den dybe tallerken- Tåler opvaskemaskine- Tåler mikroovn. Køb Dybe tallerkner og andre Tallerkner fra Royal Design. -
House Doctor Lake serveringsfad Ø30 cm Grå
House Doctor Lake serveringsfad Ø30 cm Grå -
Serveringsbræt, Hddiva, Blå
299 kr
Læs mere herPrimær: Stentøj (100%) -
House Doctor Rain tallerken Ø27 cm 2-pak Grøn
House Doctor Rain tallerken Ø27 cm 2-pak Grøn -
House doctor Rustic Suppetallerken
82 kr
Læs mere herDe flotte stentøjs suppetallerkner fra House Doctor vil med sikkerhed kun pryde din opdækning. Tallerkenen er håndfremstillet, hvilket giver unikke karaktertræk på hver eneste tallerken. De er skabt med rustik elegance, så de passer ind i ethvert nordisk